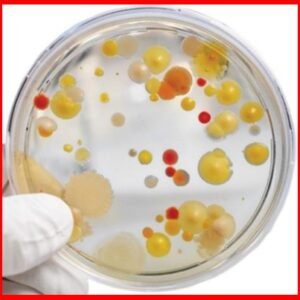

Molecular Biology
Product Category
- Uncategorized55 products
- Agriculture7272 products
- Agriculture Equipment7272 products
- Equipment8686 products
- equipmet88 products
- Food Safety2121 products
- Food Safety Equipment2121 products
- Genomic Services11 product
- infertility Consumables8484 products
- Infertility Equipment4343 products
- Lab Diagnostics9292 products
- Lab Diagnostics Consumables7979 products
- Lab Diagnostics Equipment1313 products
- Lab Wares108108 products
- Molecular Biology317317 products
- Molecular Biology Equipment9191 products
- Molecular Biology Services5757 products
- Molecular Diagnostics1717 products
- Molecular Diagnostics Equipment1616 products
- Molecular Diagnostics Services11 product